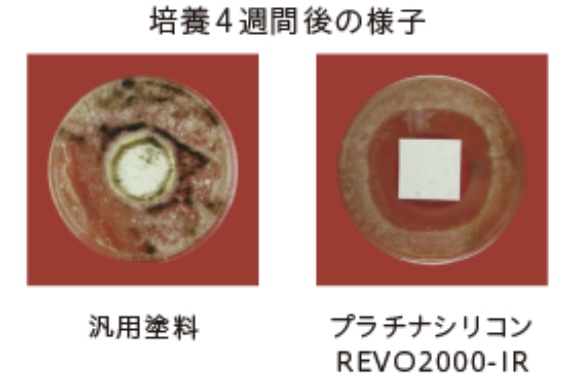
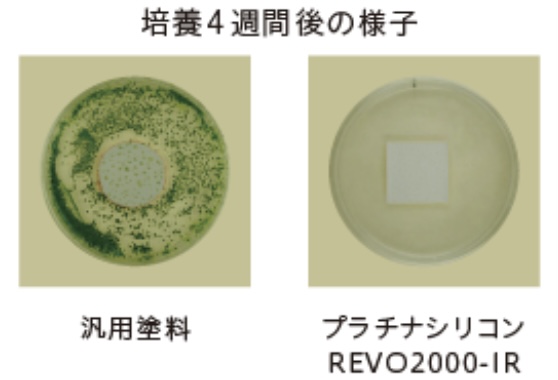

スタッフブログ
【外壁用塗料】プラチナシリコンREVO2000-IR
2026.03.25
スタッフブログ
大村市で外壁塗装・屋根塗装を専門に行っている【プロタイムズ大村店】です。
当ブログでは、外壁の劣化症状の見分け方や塗料の選び方、
工事の適切なタイミングなど、住まいを長持ちさせるための役立つ情報を発信しています。
これから外壁塗装・屋根塗装・内装・雨漏れ、その他小工事を検討されている方は、
ぜひ参考にしてください!
【プラチナシリコンREVO2000-IR】

建物を長期間守るために必要な機能を高レベルで発揮する、
高耐候ハイクラスシリコン塗料。
特徴・・『耐候性』
紫外線などの劣化要因に対して耐性を発揮し建物を保護
促進耐候性試験(キセノンランプ)において約14~17年(期待耐用年数)
経過後も光沢保持率80%以上を保持。塗膜の劣化要因である紫外線・雨に
対して、耐候性を発揮し、建物を長期間にわたって保護します。

※あくまで試験環境下における推測値であり、耐候性を保証するものでは
ありません。実際の自然ばく露環境下では、下地の状態、施工方法、気象条件により
耐候性は異なる場合があります。
🔸シリコン成分3倍配合
紫外線等の劣化要因に強いシリコン成分(シロキサン結合)を多く配合
しています。
※一般的なシリコン塗料との比較

特徴・・『低汚染性』
汚れの付着を抑え、建物の美観を保つ
塗膜表面に汚れが付きにくい特殊構造のシリコン樹脂を採用。
一般的な低汚染シリコン塗料と比較して雨筋汚れが付きにくく、
塗り替え後の美しさを保持することが確認されています。

特徴・・『防カビ・防藻性』
美観を損なう「カビ」「藻」の発生を抑え美観維持に貢献
「JIS Z 2911かび抵抗性試験方法」および「藻抵抗性試験(社内試験による)」に合格。
通常配合されている防カビ・防藻剤に加えて、効果を高める薬剤を配合。
より多くの種類の菌類に対して、効果を発揮し、防カビ・防藻性を
長期間にわたって維持します。
〈カビ〉
〈藻〉
特徴・・『遮熱性』
特殊遮熱無機顔料の使用によりすぐれた遮熱性を発揮
太陽光の波長のうち温度上昇を抑えます。
※アステック標準色8113トゥルーホワイト以外に全色で使用。
※建物構造、断熱構造、開口部(ガラス窓)の大きさ・数によって
温度変化の程度に差がでます。
〈プラチナシリコンREVO2000-IR〉

〈従来の塗料〉

🔸遮熱性比較試験
塗料を塗布したサイディングに約1時間ランプ照射し、塗膜の表面温度を測定。
一般的な塗料と比較して、約29℃の温度差があり、すぐれた遮熱性を発揮する
ことが確認されました。

大切なお住まい長く、美しく保つためには、
定期的な外壁・屋根塗装が欠かせません。
大村市で外壁塗装・屋根塗装など、ご検討中の方は、
ぜひ弊社へお気軽にご相談ください。
劣化状況を丁寧に診断し、最適な塗装プランをご提案いたします💡
【劣化診断・見積り・相談】無料🍀
株式会社ソエジマ【プロタイムズ大村店】
場所:〒856-0826 長崎県大村市水主町2-627-1
TEL:0120-066-116













